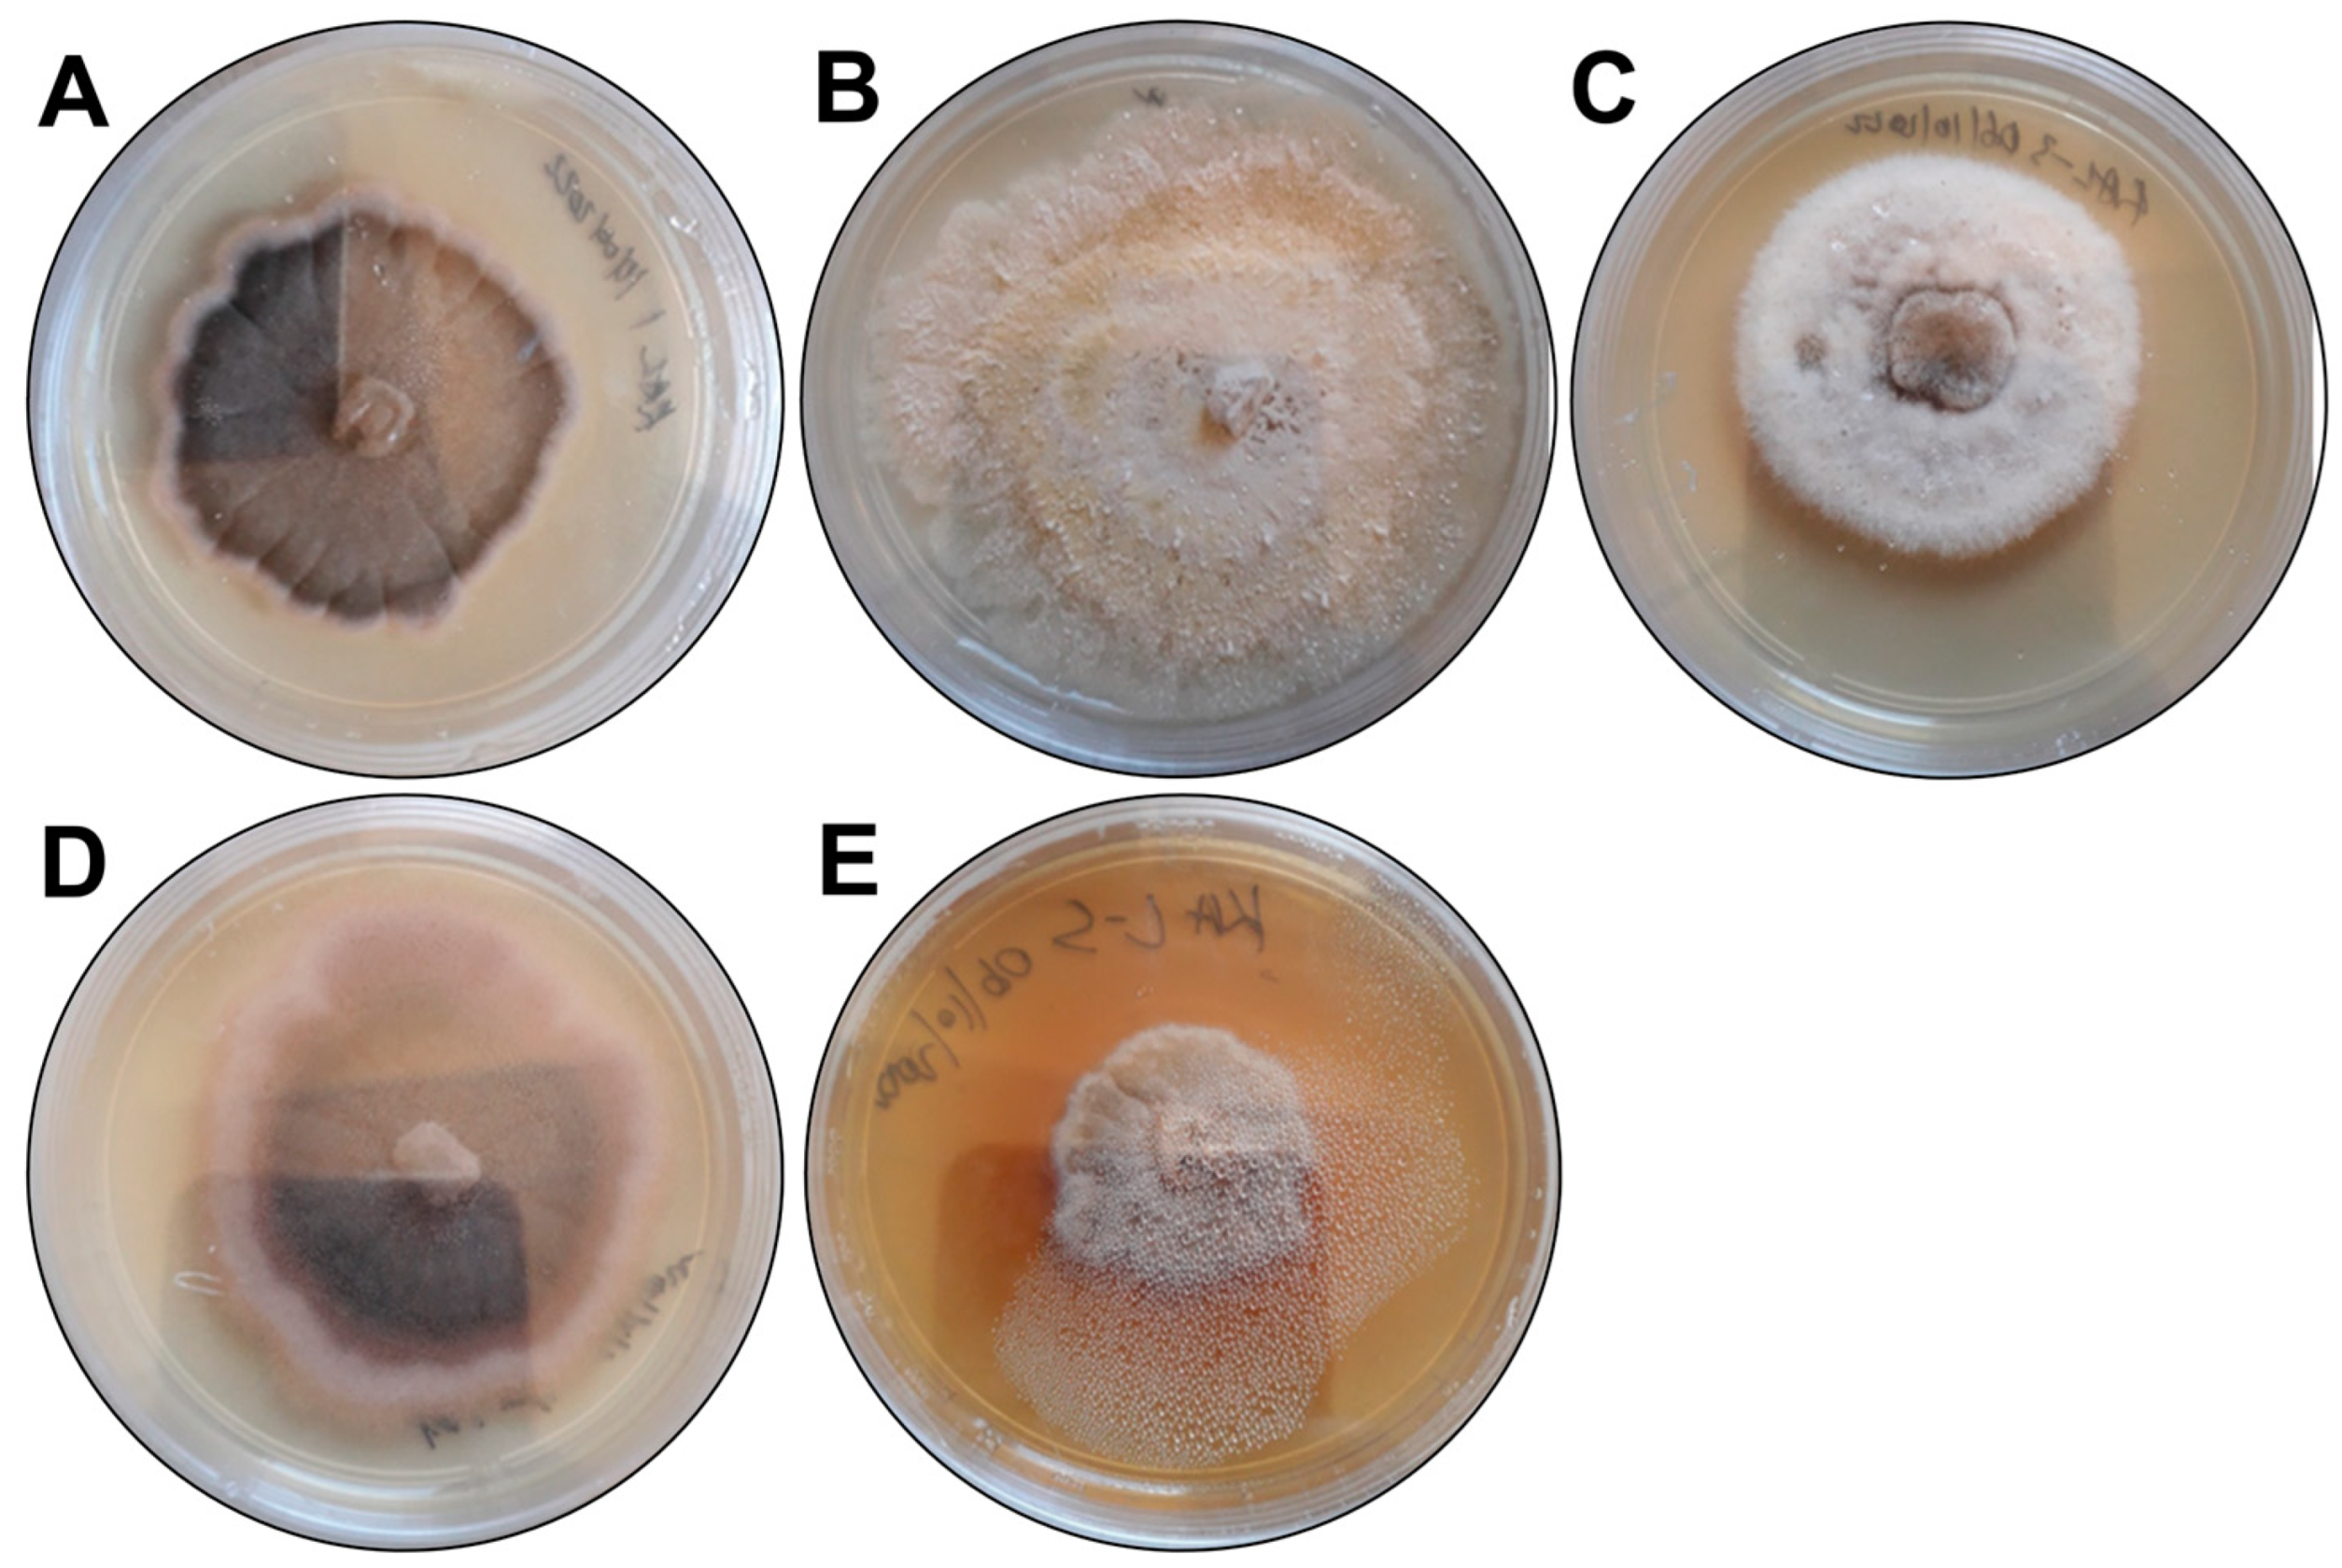
Microorganisms 13 00692 g001 Microorganisms 13 00692 g001
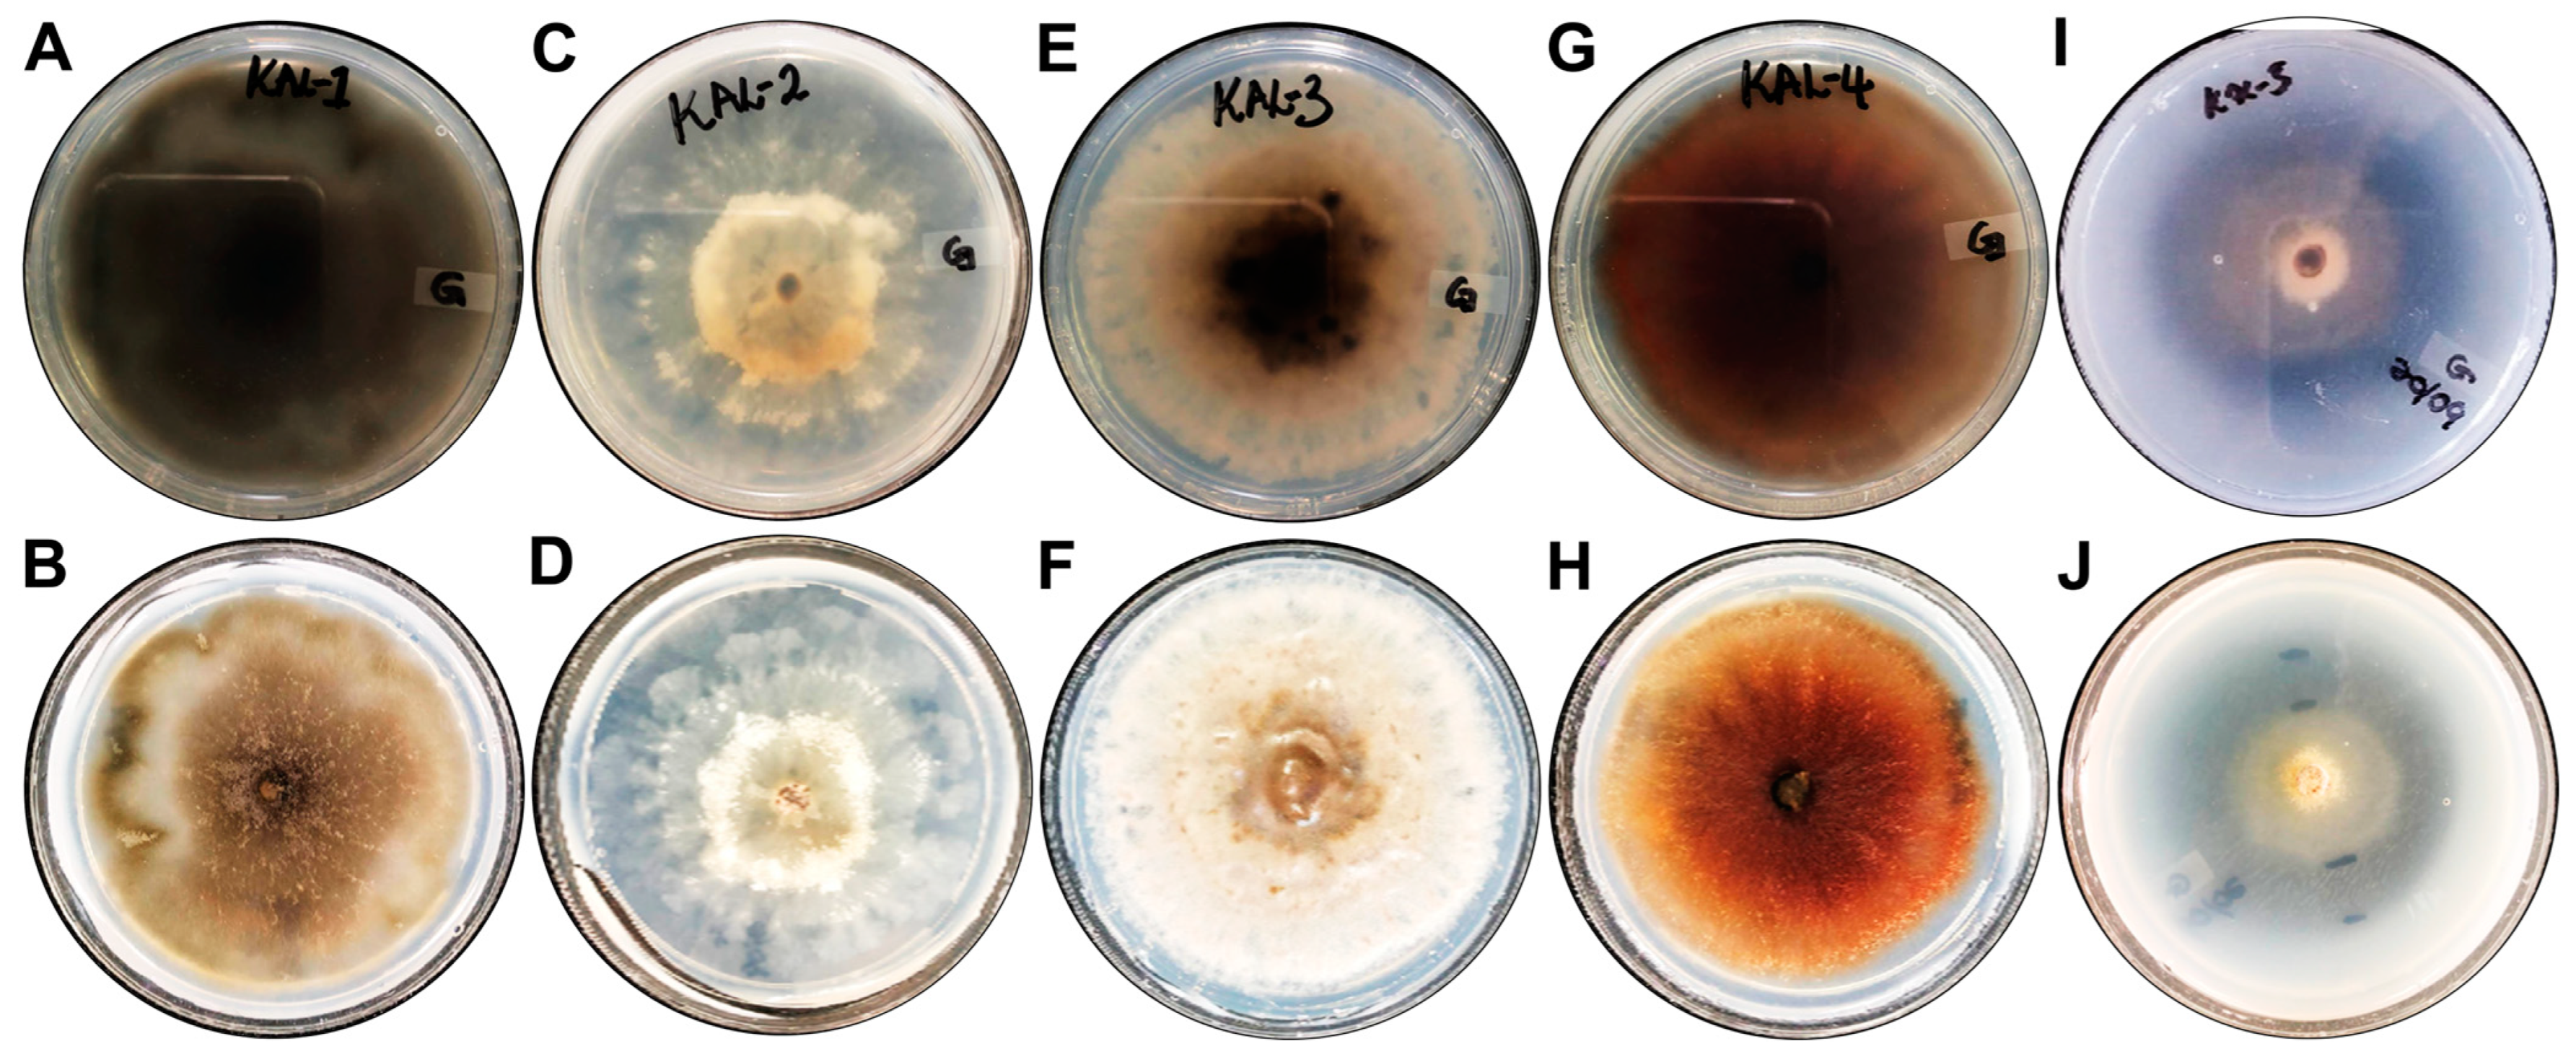
Microorganisms 13 00692 g004 Microorganisms 13 00692 g004
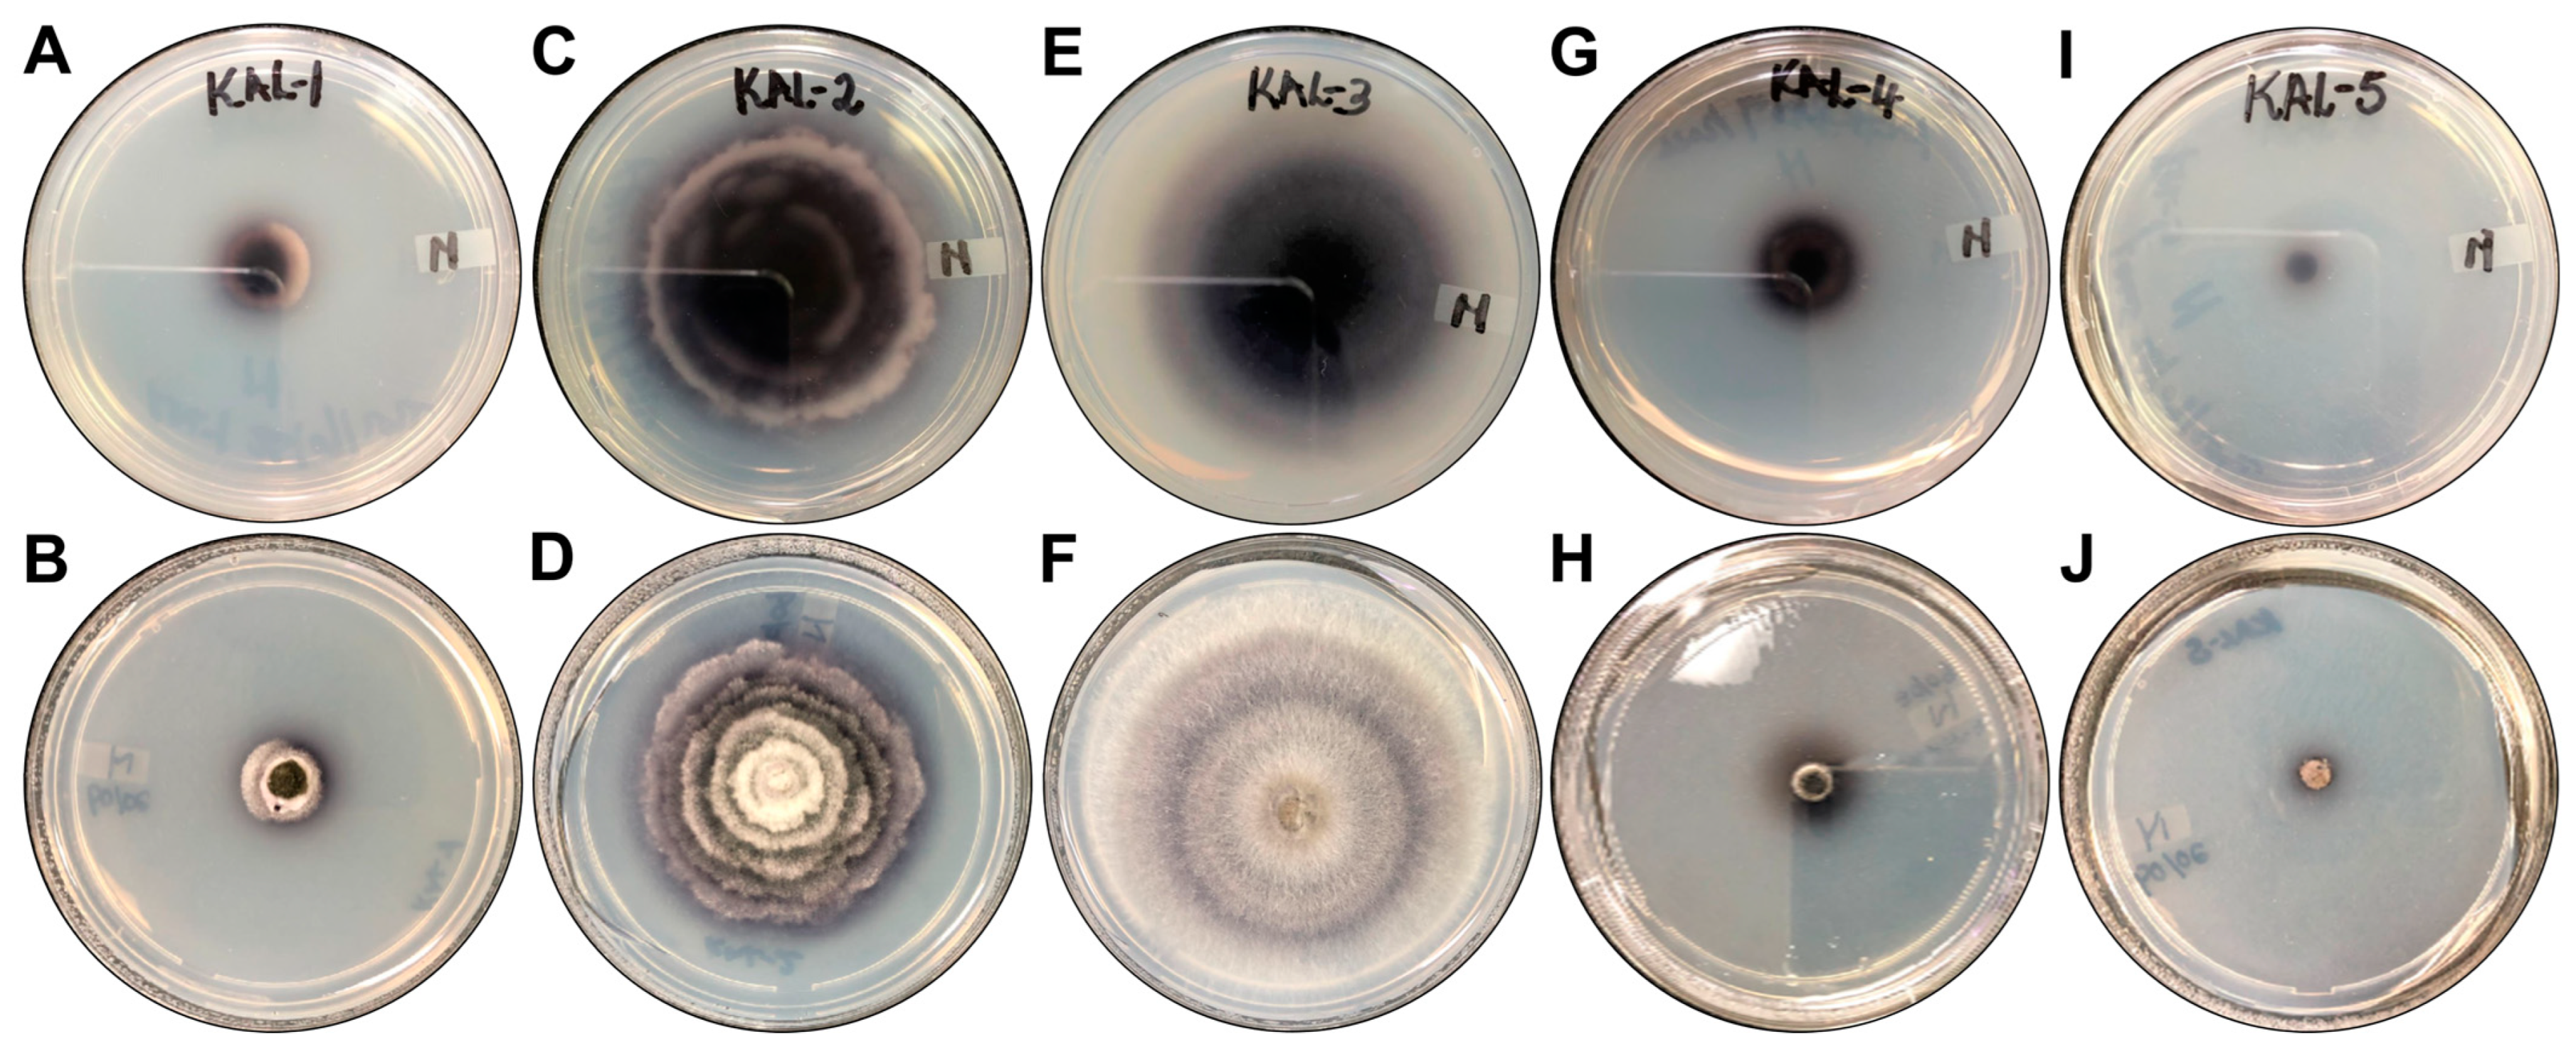
Microorganisms 13 00692 g005 Microorganisms 13 00692 g005

Exploring the Antimicrobial, Antioxidant and Extracellular Enzymatic Activities of Culturable Endophytic Fungi Isolated from the Leaves of Kirkia acuminata Oliv
Abstract
1. Introduction
2. Materials and Methods
2.1. Identification of Endophytic Fungi
2.2. Fungal Cultivation and Extraction of Metabolites
2.3. Antibacterial Activity of Endophytic Fungal Crude Extracts
2.3.1. Bacterial Test Organisms
2.3.2. Minimum Inhibitory Concentration of Crude Extracts
2.4. Antioxidant Potential of Endophytic Fungal Crude Extracts
2.4.1. Ferric Reducing Antioxidant Power (FRAP) Assay
2.4.2. DPPH Free Radical Scavenging Assay
2.5. Total Phenolic Content of Endophytic Fungal Crude Extracts
2.6. MTT (3-(4,5-Dimethylthiazol-2-yl)-2,5-diphenyltetrazolium) Assay
2.7. Enzyme-Linked Immunosorbent Assay
2.8. Extracellular Enzymatic Activity of Fungal Endophytes
2.8.1. Protease Activity
2.8.2. Laccase Activity
2.8.3. Peroxidase Activity
2.8.4. Evaluation of Protease and Laccase Production
2.9. Statistical Analysis
3. Results
3.1. Morphological and Molecular Identification of Fugal Endophytes
3.2. Antibacterial Activity of Fungal Crude Extracts
3.3. Antioxidant Activity of Crude Extracts
3.4. Total Phenolic Content of Fungal Endophyte Crude Extracts
3.5. Influence of S. rostrata KaL-4 CE on Viability Profiles and IL-6 Production in RAW 264.7
3.6. Extracellular Enzyme Production Capabilities of Fungal Endophytes
4. Discussion
5. Conclusions
Author Contributions
Funding
Institutional Review Board Statement
Informed Consent Statement
Data Availability Statement
Acknowledgments
Conflicts of Interest
References
- Moharram, A.M.; Zohri, A.A.; Omar, H.M.; Abd El-Ghani, O.A. In Vitro Assessment of Antimicrobial and Anti-Inflammatory Potential of Endophytic Fungal Metabolites Extracts. Eur. J. Biol. Res. Res. Artic. Eur. J. Biol. Res. 2017, 7, 234–244. [Google Scholar]
- Karin, M.; Lawrence, T.; Nizet, V. Innate Immunity Gone Awry: Linking Microbial Infections to Chronic Inflammation and Cancer. Cell 2006, 124, 823–835. [Google Scholar] [CrossRef] [PubMed]
- Arfeen, M.; Srivastava, A.; Srivastava, N.; Khan, R.A.; Almahmoud, S.A.; Mohammed, H.A. Design, Classification, and Adverse Effects of NSAIDs: A Review on Recent Advancements. Bioorg. Med. Chem. 2024, 112, 117899. [Google Scholar] [CrossRef]
- Manganyi, M.C.; Ateba, C.N. Untapped Potentials of Endophytic Fungi: A Review of Novel Bioactive Compounds with Biological Applications. Microorganisms 2020, 8, 1934. [Google Scholar] [CrossRef]
- Venieraki, A.; Dimou, M.; Katinakis, P. Endophytic Fungi Residing in Medicinal Plants Have the Ability to Produce the Same or Similar Pharmacologically Active Secondary Metabolites as Their Hosts. Hell. Plant Prot. J. 2017, 10, 51–66. [Google Scholar] [CrossRef]
- Kaul, S.; Gupta, S.; Ahmed, M.; Dhar, M.K. Endophytic Fungi from Medicinal Plants: A Treasure Hunt for Bioactive Metabolites. Phytochem. Rev. 2012, 11, 487–505. [Google Scholar] [CrossRef]
- Gupta, J.; Sharma, S. Endophytic Fungi: A New Hope for Drug Discovery. In New and Future Developments in Microbial Biotechnology and Bioengineering; Elsevier: Amsterdam, The Netherlands, 2020; pp. 39–49. ISBN 9780128210062. [Google Scholar]
- Burragoni, S.G.; Jeon, J. Applications of Endophytic Microbes in Agriculture, Biotechnology, Medicine, and Beyond. Microbiol. Res. 2021, 245, 126691. [Google Scholar] [CrossRef]
- Sopalun, K.; Iamtham, S. Isolation and Screening of Extracellular Enzymatic Activity of Endophytic Fungi Isolated from Thai Orchids. S. Afr. J. Bot. 2020, 134, 273–279. [Google Scholar] [CrossRef]
- Singh, R.; Kumar, M.; Mittal, A.; Mehta, P.K. Microbial Enzymes: Industrial Progress in 21st Century. 3 Biotech 2016, 6, 174. [Google Scholar] [CrossRef]
- Shubha, J.; Srinivas, C. Diversity and Extracellular Enzymes of Endophytic Fungi Associated with Cymbidium aloifolium L. African J. Biotechnol. 2017, 16, 2242–2247. [Google Scholar] [CrossRef][Green Version]
- Rai, N.; Kumari Keshri, P.; Verma, A.; Kamble, S.C.; Mishra, P.; Barik, S.; Kumar Singh, S.; Gautam, V. Plant Associated Fungal Endophytes as a Source of Natural Bioactive Compounds. Mycology 2021, 12, 139–159. [Google Scholar] [CrossRef] [PubMed]
- Aboobaker, Z.; Viljoen, A.; Chen, W.; Crous, P.W.; Maharaj, V.J.; van Vuuren, S. Endophytic Fungi Isolated from Pelargonium Sidoides DC: Antimicrobial Interaction and Isolation of a Bioactive Compound. S. Afr. J. Bot. 2019, 122, 535–542. [Google Scholar] [CrossRef]
- Maroyi, A. Kirkia acuminata Oliv.: A Review of Its Ethnobotany and Pharmacology. Afr. J. Tradit. Complement. Altern. Med. AJTCAM 2017, 14, 217–226. [Google Scholar] [CrossRef]
- van Wyk, A.S.; Prinsloo, G. Medicinal Plant Harvesting, Sustainability and Cultivation in South Africa. Biol. Conserv. 2018, 227, 335–342. [Google Scholar] [CrossRef]
- Magagula, M. University of Limpopo, Mankweng, South Africa, 2021.
- Altschul, S.F.; Madden, T.L.; Schäffer, A.A.; Zhang, J.; Zhang, Z.; Miller, W.; Lipman, D.J. Gapped BLAST and PSI-BLAST: A New Generation of Protein Database Search Programs. Nucleic Acids Res. 1997, 25, 3389–3402. [Google Scholar] [CrossRef]
- Eloff, J.N. A Sensitive and Quick Microplate Method to Determine the Minimal Inhibitory Concentration of Plant Extracts for Bacteria. Planta Med. 1998, 64, 711–713. [Google Scholar] [CrossRef]
- Arulpriya, P.; Lalitha, P.; Hemalatha, S. Cyclic Voltammetric Assessment of the Antioxidant Activity of Petroleum Ether Extract of Samanea Saman (Jacq.)Merr. Adv. Appl. Sci. Res. 2010, 1, 24–35. [Google Scholar]
- Baliyan, S.; Mukherjee, R.; Priyadarshini, A.; Vibhuti, A.; Gupta, A.; Pandey, R.P.; Chang, C.M. Determination of Antioxidants by DPPH Radical Scavenging Activity and Quantitative Phytochemical Analysis of Ficus Religiosa. Molecules 2022, 27, 1326. [Google Scholar] [CrossRef]
- Tambe, V.D.; Bhambar, R.S. Estimation of Total Phenol, Tannin, Alkaloid and Flavonoid in Hibiscus Tiliaceus Linn. Wood Extracts. Res. Rev. J. Pharmacogn. Phytochem. 2014, 2, 41–47. [Google Scholar]
- van Meerloo, J.; Kaspers, G.J.L.; Cloos, J. Cell Sensitivity Assays: The MTT Assay BT—Cancer Cell Culture: Methods and Protocols; Cree, I.A., Ed.; Humana Press: Totowa, NJ, USA, 2011; pp. 237–245. ISBN 978-1-61779-080-5. [Google Scholar]
- Baek, S.; Park, T.; Kang, M.; Park, D. Anti-Inflammatory Activity and ROS Regulation. Molecules 2020, 25, 4089. [Google Scholar] [CrossRef]
- Sunitha, V.H.; Nirmala Devi, D.; Srinivas, C. Extracellular Enzymatic Activity of Endophytic Fungal Strains Isolated from Medicinal Plants. World J. Agric. Sci. 2013, 9, 1–9. [Google Scholar] [CrossRef]
- Hawar, S.N. Extracellular Enzyme of Endophytic Fungi Isolated from Ziziphus Spina Leaves as Medicinal Plant. Int. J. Biomater. 2022, 2022, 2135927. [Google Scholar] [CrossRef] [PubMed]
- Attia, E.Z.; Farouk, H.M.; Abdelmohsen, U.R.; El-Katatny, M.H. Antimicrobial and Extracellular Oxidative Enzyme Activities of Endophytic Fungi Isolated from Alfalfa (Medicago sativa) Assisted by Metabolic Profiling. S. Afr. J. Bot. 2020, 134, 156–162. [Google Scholar] [CrossRef]
- Chai, C.H.; Hong, C.F.; Huang, J.W. Identification and Characterization of a Multifunctional Biocontrol Agent, Streptomyces Griseorubiginosus LJS06, Against Cucumber Anthracnose. Front. Microbiol. 2022, 13, 923276. [Google Scholar] [CrossRef]
- Masoko, P. Ethnobotanical Study of Some Selected Medicinal Plants Used by Traditional Healers in Limpopo Province (South Africa). Am. J. Res. Commun. 2013, 1, 8–23. [Google Scholar]
- Mulholland, D.A.; Cheplogoi, P.; Crouch, N.R. Secondary Metabolites from Kirkia acuminata and Kirkia wilmsii (Kirkiaceae). Biochem. Syst. Ecol. 2003, 31, 793–797. [Google Scholar] [CrossRef]
- Mabadahanye, K.; Bhembe, N.L.; Green, E. Crude Extracts Activity of Three Selected Medicinal Plants from the Venda Region against Some Pathogenic Organisms. Afr. Health Sci. 2022, 22, 717–727. [Google Scholar] [CrossRef]
- dos Reis, J.B.A.; Lorenzi, A.S.; do Vale, H.M.M. Methods Used for the Study of Endophytic Fungi: A Review on Methodologies and Challenges, and Associated Tips. Arch. Microbiol. 2022, 204, 675. [Google Scholar] [CrossRef]
- Sishuba, A.; Leboko, J.; Ateba, C.N.; Manganyi, M.C. First Report: Diversity of Endophytic Fungi Possessing Antifungal Activity Isolated from Native Kougoed (Sceletium tortuosum L.). Mycobiology 2021, 49, 89–94. [Google Scholar] [CrossRef]
- Lücking, R.; Aime, M.C.; Robbertse, B.; Miller, A.N.; Ariyawansa, H.A.; Aoki, T.; Cardinali, G.; Crous, P.W.; Druzhinina, I.S.; Geiser, D.M.; et al. Unambiguous Identification of Fungi: Where Do We Stand and How Accurate and Precise Is Fungal DNA Barcoding? IMA Fungus 2020, 11, 14. [Google Scholar] [CrossRef]
- Manganyi, M.C.; Regnier, T.; Kumar, A.; Bezuidenhout, C.C.; Ateba, C.N. Biodiversity and Antibacterial Screening of Endophytic Fungi Isolated from Pelargonium sidoide. S. Afr. J. Bot. 2018, 116, 192–199. [Google Scholar] [CrossRef]
- Abdalla, M.A.; Aro, A.O.; Gado, D.; Passari, A.K.; Mishra, V.K.; Singh, B.P.; McGaw, L.J. Isolation of Endophytic Fungi from South African Plants, and Screening for Their Antimicrobial and Extracellular Enzymatic Activities and Presence of Type I Polyketide Synthases. S. Afr. J. Bot. 2020, 134, 336–342. [Google Scholar] [CrossRef]
- Fanele, A.; Ndlovu, S.I. Endophytic Fungal Species Nigrospora Oryzae and Alternaria Alternata Exhibit Antimicrobial Activity against Gram-Positive and Gram-Negative Multi-Drug Resistant Clinical Bacterial Isolates. BMC Complement. Med. Ther. 2023, 23, 323. [Google Scholar] [CrossRef]
- Manganyi, M.C.; Regnier, T.; Tchatchouang, C.D.K.; Bezuidenhout, C.C.; Ateba, C.N. Antibacterial Activity of Endophytic Fungi Isolated from Sceletium tortuosum L. (Kougoed). Ann. Microbiol. 2019, 69, 659–663. [Google Scholar] [CrossRef]
- Digra, S.; Nonzom, S. An Insight into Endophytic Antimicrobial Compounds: An Updated Analysis; Springer Nature: Singapore; Berlin/Heidelberg, Germany, 2023; Volume 17, ISBN 1181602300824. [Google Scholar]
- Silva, D.P.D.; Cardoso, M.S.; Macedo, A.J. Endophytic Fungi as a Source of Antibacterial Compounds—A Focus on Gram-Negative Bacteria. Antibiotics 2022, 11, 1509. [Google Scholar] [CrossRef]
- Mazzulli, T.; Skulnick, M.; Small, G.; Marshall, W.; Hoban, D.J.; Zhanel, G.G.; Finn, S.; Low, D.E. Susceptibility of Community Gram-Negative Urinary Tract Isolates to Mecillinam and Other Oral Agents. Can. J. Infect. Dis. 2001, 12, 289–292. [Google Scholar] [CrossRef]
- Breijyeh, Z.; Jubeh, B.; Karaman, R. Resistance of Gram-Negative Bacteria to Current Antibacterial Agents and Approaches to Resolve It. Molecules 2020, 25, 1340. [Google Scholar] [CrossRef]
- Gagana, S.L.; Kumaraswamy, B.E.; Shivanna, M.B. Diversity, Antibacterial and Antioxidant Activities of the Fungal Endophytes Associated with Schleichera oleosa (Lour.) Merr. S. Afr. J. Bot. 2020, 134, 369–381. [Google Scholar] [CrossRef]
- Nxumalo, C.I.; Ngidi, L.S.; Siyabonga, J.; Shandu, E. Isolation of Endophytic Bacteria from the Leaves of Anredera Cordifolia CIX1 for Metabolites and Their Biological Activities. BMC Complement. Med. Ther. 2020, 20, 300. [Google Scholar]
- Barfour, A.F.; Mensah, A.Y.; Asante-Kwatia, E.; Danquah, C.A.; Anokwah, D.; Adjei, S.; Baah, M.K.; Mensah, M.L.K. Antibacterial, Antibiofilm, and Efflux Pump Inhibitory Properties of the Crude Extract and Fractions from Acacia Macrostachya Stem Bark. Sci. World J. 2021, 2021, 5381993. [Google Scholar] [CrossRef]
- Attia, E.Z.; Khalifa, B.A.; Shaban, G.M.; Abdelraheem, W.M.; Mustafa, M.; Abdelmohsen, U.R.; El-Katatny, M.H. Discovering the Chemical Profile, Antimicrobial and Antibiofilm Potentials of the Endophytic Fungus Penicillium Chrysogenum Isolated from Artemisia judaica L. Assisted with Docking Studies. S. Afr. J. Bot. 2022, 151, 218–227. [Google Scholar] [CrossRef]
- Rabha, J.; Chetri, B.K.; Das, S.; Jha, D.K. In-Vitro and in-Silico Evaluation of Antimicrobial and Antibiofilm Secondary Metabolites of a Novel Fungal Endophyte, Albophoma Sp. BAPR5. S. Afr. J. Bot. 2023, 158, 347–368. [Google Scholar] [CrossRef]
- Chaudhary, P.; Janmeda, P.; Docea, A.O.; Yeskaliyeva, B.; Abdull Razis, A.F.; Modu, B.; Calina, D.; Sharifi-Rad, J. Oxidative Stress, Free Radicals and Antioxidants: Potential Crosstalk in the Pathophysiology of Human Diseases. Front. Chem. 2023, 11, 1158198. [Google Scholar] [CrossRef]
- Onyekachukwu, R.; Timothy, A.; Chidike, P.; Ezike, T.C.; Uzoechina, J.O. Exploring the Antioxidant Potential of Endophytic Fungi: A Review on Methods for Extraction and Quantification of Total Antioxidant Capacity (TAC). 3 Biotech 2024, 14, 127. [Google Scholar] [CrossRef]
- Pan, F.; Su, T.; Cai, S.; Wu, W. Fungal Endophyte-Derived Fritillaria Unibracteata Var. Wabuensis: Diversity, Antioxidant Capacities in Vitro and Relations to Phenolic, Flavonoid or Saponin Compounds. Sci. Rep. 2017, 7, 42008. [Google Scholar] [CrossRef]
- Sharaf, M.H.; Abdelaziz, A.M.; Kalaba, M.H.; Radwan, A.A.; Hashem, A.H. Antimicrobial, Antioxidant, Cytotoxic Activities and Phytochemical Analysis of Fungal Endophytes Isolated from Ocimum basilicum. Appl. Biochem. Biotechnol. 2022, 194, 1271–1289. [Google Scholar] [CrossRef]
- Vuolo, M.M.; Lima, V.S.; Maróstica Junior, M.R. Phenolic Compounds; Elsevier Inc.: Amsterdam, The Netherlands, 2019; ISBN 9780128147740. [Google Scholar]
- Ghazi-yaker, A.; Kraak, B.; Houbraken, J.; Nabti, E.; Cruz, C.; Saadoun, N.; Houali, K. In Vitro Antioxidant and Antibacterial Activities of Ethyl Acetate Extracts of Ziziphus Lotus Leaves and Five Associated Endophytic Fungi. Microorganisms 2024, 12, 2671. [Google Scholar] [CrossRef]
- Yadav, M.; Yadav, A.; Yadav, J.P. In Vitro Antioxidant Activity and Total Phenolic Content of Endophytic Fungi Isolated from Eugenia Jambolana Lam. Asian Pac. J. Trop. Med. 2014, 7, S256–S261. [Google Scholar] [CrossRef]
- Makola, R.T.; Mbazima, V.G.; Mokgotho, M.P.; Gallicchio, V.S.; Matsebatlela, T.M. The Effect of Lithium on Inflammation-Associated Genes in Lipopolysaccharide-Activated Raw 264.7 Macrophages. Int. J. Inflam. 2020, 2020, 8340195. [Google Scholar] [CrossRef]
- Reuter, S.; Gupta, S.C.; Chaturvedi, M.M.; Aggarwal, B.B. Oxidative Stress, Inflammation, and Cancer: How Are They Linked? Free Radic. Biol. Med. 2010, 49, 1603–1616. [Google Scholar] [CrossRef]
- Khan, A.L.; Gilani, S.A.; Waqas, M.; Al-Hosni, K.; Al-Khiziri, S.; Kim, Y.H.; Ali, L.; Kang, S.M.; Asaf, S.; Shahzad, R.; et al. Endophytes from Medicinal Plants and Their Potential for Producing Indole Acetic Acid, Improving Seed Germination and Mitigating Oxidative Stress. J. Zhejiang Univ. Sci. B 2017, 18, 125–137. [Google Scholar] [CrossRef] [PubMed]
- Chandra, H.; Yadav, A.; Prasad, R.; Kalra, S.J.S.; Singh, A.; Bhardwaj, N.; Gupta, K.K. Fungal Endophytes from Medicinal Plants Acting as Natural Therapeutic Reservoir. The Microbe 2024, 3, 100073. [Google Scholar] [CrossRef]
- Uzma, F.; Mohan, C.D.; Hashem, A.; Konappa, N.M.; Rangappa, S.; Kamath, P.V.; Singh, B.P.; Mudili, V.; Gupta, V.K.; Siddaiah, C.N.; et al. Endophytic Fungi-Alternative Sources of Cytotoxic Compounds: A Review. Front. Pharmacol. 2018, 9, 309. [Google Scholar] [CrossRef]
- Koopklang, K.; Choodej, S.; Hantanong, S.; Intayot, R.; Jungsuttiwong, S.; Insumran, Y.; Ngamrojanavanich, N.; Pudhom, K. Anti-Inflammatory Properties of Oxygenated Isocoumarins and Xanthone from Thai Mangrove-Associated Endophytic Fungus Setosphaeria Rostrata. Molecules 2024, 29, 603. [Google Scholar] [CrossRef]
- Bhadra, F.; Gupta, A.; Vasundhara, M.; Reddy, M.S. Endophytic Fungi: A Potential Source of Industrial Enzyme Producers. 3 Biotech 2022, 12, 86. [Google Scholar] [CrossRef]
- Schneider, W.D.H.; Fontana, R.C.; Mendonça, S.; de Siqueira, F.G.; Dillon, A.J.P.; Camassola, M. High Level Production of Laccases and Peroxidases from the Newly Isolated White-Rot Basidiomycete Marasmiellus Palmivorus VE111 in a Stirred-Tank Bioreactor in Response to Different Carbon and Nitrogen Sources. Process Biochem. 2018, 69, 1–11. [Google Scholar] [CrossRef]
- Indarmawan, T.; Mustopa, A.Z.; Budiarto, B.R.; Tarman, K. Antibacterial Activity of Extracellular Protease Isolated From an Algicolous Fungus Xylaria Psidii KT30 Against Gram-Positive Bacteria. HAYATI J. Biosci. 2016, 23, 73–78. [Google Scholar] [CrossRef]
- Anita, S.H.; Asishe, A.; Syafriana, V.; Febriani, A.; Zulfiana, D.; Oktaviani, M.; Nurhayat, O.D.; Yanto, D.H.Y. Hand Sanitizer Gel Formulation with Laccase Enzyme as an Antibacterial Against Staphylococcus Aureus and Escherichia Coli. Borneo J. Pharm. 2022, 5, 375–383. [Google Scholar] [CrossRef]
- de Oliveira, F.K.; Santos, L.O.; Buffon, J.G. Mechanism of Action, Sources, and Application of Peroxidases. Food Res. Int. 2021, 143, 110266. [Google Scholar] [CrossRef]

| Isolate Code | Colony Description | Predicted Species | GenBank Best Match | |
|---|---|---|---|---|
| Accession Number | % Identity | |||
| KaL-1 | Grey irregular colony with black trim surrounded by white trim. Colony surface is raised and rough. | Setosphaeria rostrata | LT837843.1 | 100 |
| KaL-2 | Whitish-brown irregular colony with flat and rough surface. | Diaporthe species | MT355681.1 | 99.31 |
| KaL-3 | White circular colony with raised and soft surface. | Corynespora cassiicola | MK139711.1 | 100 |
| KaL-4 | Grey irregular colony surrounded by black, red and white trims, respectively. Colony surface is raised and rough. | Setosphaeria rostrata | LT837843.1 | 100 |
| KaL-5 | Whitish-brown irregular colony with raised and rough surface. Colour diffusing into medium. | Diaporthe species | MZ151534.1 | 99.65 |
| Endophytic Fungi | E. coli | K. pneumoniae | P. aeruginosa |
|---|---|---|---|
| Setosphaeria rostrata KaL-1 | 1.25 | 1.25 | 0.63 |
| Diaporthe sp. KaL-2 | 1.25 | 1.25 | 0.63 |
| Corynespora cassiicola KaL-3 | 1.25 | 1.25 | 1.25 |
| Setosphaeria rostrata KaL-4 | 1.25 | 1.25 | 1.25 |
| Diaporthe sp. KaL-5 | 0.63 | 1.25 | 0.63 |
| Chloramphenicol | 0.02 | 0.02 | 0.02 |
| Endophytic Fungi | TPC (mg GAE/g) |
|---|---|
| Setosphaeria rostrata KaL-1 | 79.64 ± 2.36 |
| Diaporthe sp. KaL-2 | 102.05 ± 1.77 |
| Corynespora cassiicola KaL-3 | 143.97 ± 7.67 |
| Setosphaeria rostrata KaL-4 | 373.80 ± 12.39 |
| Diaporthe sp. KaL-5 | 231.42 ± 7.08 |
| Endophytic Fungi | Protease Activity | Laccase Activity |
|---|---|---|
| Setosphaeria rostrata | − | 0.43 ± 0.29 |
| Diaporthe sp. | − | 0.14 ± 0.01 |
| Corynespora cassiicola | − | + |
| Setosphaeria rostrata | − | 0.49 ± 0.02 |
| Diaporthe sp. | 0.66 ± 0.05 | 1.15 ± 0.13 |
| Endophytic Fungi | Peroxidase Activity |
|---|---|
| Setosphaeria rostrata KaL-1 | + |
| Diaporthe sp. KaL-2 | + |
| Corynespora cassiicola KaL-3 | + |
| Setosphaeria rostrata KaL-4 | + |
| Diaporthe sp. KaL-5 | + |
Disclaimer/Publisher’s Note: The statements, opinions and data contained in all publications are solely those of the individual author(s) and contributor(s) and not of MDPI and/or the editor(s). MDPI and/or the editor(s) disclaim responsibility for any injury to people or property resulting from any ideas, methods, instructions or products referred to in the content. |
© 2025 by the authors. Licensee MDPI, Basel, Switzerland. This article is an open access article distributed under the terms and conditions of the Creative Commons Attribution (CC BY) license (https://creativecommons.org/licenses/by/4.0/).
Share and Cite
Kubayi, S.; Makola, R.T.; Dithebe, K. Exploring the Antimicrobial, Antioxidant and Extracellular Enzymatic Activities of Culturable Endophytic Fungi Isolated from the Leaves of Kirkia acuminata Oliv. Microorganisms 2025, 13, 692. https://doi.org/10.3390/microorganisms13030692
Kubayi S, Makola RT, Dithebe K. Exploring the Antimicrobial, Antioxidant and Extracellular Enzymatic Activities of Culturable Endophytic Fungi Isolated from the Leaves of Kirkia acuminata Oliv. Microorganisms. 2025; 13(3):692. https://doi.org/10.3390/microorganisms13030692
Chicago/Turabian StyleKubayi, Sagwadi, Raymond Tshepiso Makola, and Khumiso Dithebe. 2025. "Exploring the Antimicrobial, Antioxidant and Extracellular Enzymatic Activities of Culturable Endophytic Fungi Isolated from the Leaves of Kirkia acuminata Oliv" Microorganisms 13, no. 3: 692. https://doi.org/10.3390/microorganisms13030692
APA StyleKubayi, S., Makola, R. T., & Dithebe, K. (2025). Exploring the Antimicrobial, Antioxidant and Extracellular Enzymatic Activities of Culturable Endophytic Fungi Isolated from the Leaves of Kirkia acuminata Oliv. Microorganisms, 13(3), 692. https://doi.org/10.3390/microorganisms13030692

